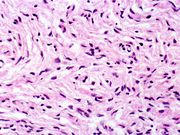

File list
This special page shows all uploaded files.
| Date | Name | Thumbnail | Size | User | Description | Versions |
|---|---|---|---|---|---|---|
| 16:47, 19 August 2013 | IPLab4Thromboembolus3.jpg (file) |  |
64 KB | Seung Park | This is a gross photograph of portions of muscle from the legs including sections of leg veins. Note that the leg veins contain thrombus (arrows). | 1 |
| 16:47, 19 August 2013 | IPLab4Thromboembolus4.jpg (file) |  |
47 KB | Seung Park | This is a low-power photomicrograph of lung. A large thrombus is lodged at this branch point in the pulmonary artery. Note the hemorrhage and congestion in the surrounding lung parenchyma. | 1 |
| 16:48, 19 August 2013 | IPLab4Thromboembolus5.jpg (file) |  |
66 KB | Seung Park | This is a photomicrograph of the wall of the pulmonary artery (1) containing the thromboembolus. In this case the artery wall looks normal. If this was a thrombus instead of a thromboembolus, you would expect to see some damage in the artery wall that ... | 1 |
| 16:48, 19 August 2013 | IPLab4Thromboembolus6.jpg (file) |  |
61 KB | Seung Park | This is a low-power photomicrograph of the infarcted lung. The tissue is congested and has a very bland appearance due to coagulation necrosis of the lung parenchyma. You can still see the outlines of the alveoli and the cells that make-up the alveoli ... | 1 |
| 16:48, 19 August 2013 | IPLab4Thromboembolus7.jpg (file) |  |
64 KB | Seung Park | This is a gross photograph of an infarcted testis. Because of the anatomy of the blood supply to the testis, torsion or the blood vessels often leads to venous occlusion (due to compression of the thin walled veins) but not arterial occlusion. Thus, bl... | 1 |
| 16:49, 19 August 2013 | IPLab4Thromboembolus8.jpg (file) |  |
65 KB | Seung Park | This is a gross photograph of cut section of testis from previous image. The tissue is filled with blood. | 1 |
| 16:49, 19 August 2013 | IPLab4Thromboembolus9.jpg (file) |  |
47 KB | Seung Park | This is a gross photograph of an opened abdomen at autopsy demonstrating loops of infarcted bowel (arrow). Vascular occlusion can lead to ischemic necrosis of the bowel. In this case, a section of bowel herniated through a fibrous connective tissue ban... | 1 |
| 16:50, 19 August 2013 | IPLab4Thromboembolus10.jpg (file) |  |
52 KB | Seung Park | This is a gross photograph of the fibrous band between the uterus and adjacent tissues. This fibrous scar tissue is probably left over from a previous surgery or an infection. A loop of bowel herniated through the opening produced by this fibrous band ... | 1 |
| 16:53, 19 August 2013 | IPLab2FattyChange1.jpg (file) |  |
42 KB | Peter Anderson | This gross photograph of liver tissue illustrates the yellowish color of the liver parenchyma. The yellow color indicates high fat content in this tissue. Compare this with the normal dark red color of liver. | 1 |
| 16:54, 19 August 2013 | IPLab4SepticEmboli1.jpg (file) |  |
68 KB | Seung Park | This gross photograph of lung demonstrates microabscesses due to septic embolization. Note the small 2 to 3-mm lesions scattered throughout this lung tissue (arrows). | 1 |
| 16:54, 19 August 2013 | IPLab2FattyChange2.jpg (file) |  |
22 KB | Peter Anderson | This low-power photomicrograph of liver illustrates a very pale-staining section with a uniform appearance throughout the section. | 1 |
| 16:54, 19 August 2013 | IPLab4SepticEmboli2.jpg (file) |  |
35 KB | Seung Park | This is a gross photograph of myocardium with multiple embolic lesions scattered throughout the left and right ventricles. | 1 |
| 16:55, 19 August 2013 | IPLab4SepticEmboli3.jpg (file) |  |
45 KB | Seung Park | This low-power photomicrograph shows a section of lung on the left and myocardium on the right. Both pieces of tissue have multiple embolic lesions seen as blue staining areas with massive infiltration of inflammatory cells (arrows). | 1 |
| 16:55, 19 August 2013 | IPLab4SepticEmboli4.jpg (file) |  |
58 KB | Seung Park | This is a higher-power photomicrograph of the focal lesions in the lung produced by the septic emboli. Note these are clearly demarcated from the relatively normal surrounding lung tissue. | 1 |
| 16:55, 19 August 2013 | IPLab2FattyChange3.jpg (file) |  |
73 KB | Peter Anderson | Another low-power photomicrograph illustrates again the pale, washed-out appearance of this tissue. Notice the numerous holes throughout the tissue. There are accumulations of inflammatory cells (arrows) around portal tracts. | 1 |
| 16:55, 19 August 2013 | IPLab4SepticEmboli5.jpg (file) |  |
69 KB | Seung Park | This is a higher-power photomicrograph of one of these septic abscesses illustrating the colonies of bacteria within necrotic cellular debris (arrows). This is typical of an abscess. | 1 |
| 16:56, 19 August 2013 | IPLab2FattyChange4.jpg (file) |  |
77 KB | Peter Anderson | A higher-power photomicrograph illustrates more clearly the inflammatory cells (arrows) around the portal areas. | 1 |
| 16:56, 19 August 2013 | IPLab4SepticEmboli6.jpg (file) |  |
76 KB | Seung Park | This is a low-power photomicrograph of myocardium with septic abscesses (arrows). | 1 |
| 16:56, 19 August 2013 | IPLab4SepticEmboli7.jpg (file) |  |
81 KB | Seung Park | This is a higher-power photomicrograph of the abscess within the myocardium illustrating colonies of bacteria as the dark blue-staining material (arrow). | 1 |
| 16:56, 19 August 2013 | IPLab2FattyChange5.jpg (file) |  |
75 KB | Peter Anderson | This higher-power photomicrograph of the centrilobular area gives the appearance of fatty tissue, as indicated by many empty spaces. Very few normal liver cells can be seen in this slide. A few more normal-appearing hepatocytes are present at the left ... | 1 |
| 16:56, 19 August 2013 | IPLab4SepticEmboli8.jpg (file) |  |
43 KB | Seung Park | This is a high-powered photomicrograph of a myocardial abscess stained with a special tissue Gram stain (Brown & Brenn) to illustrate the colonies of bacteria in this myocardial tissue (arrows). | 1 |
| 16:57, 19 August 2013 | IPLab2FattyChange6.jpg (file) |  |
67 KB | Peter Anderson | Another view at the same power illustrates the proliferation of bile ducts in the interlobular and perichordal regions (arrows). | 1 |
| 16:58, 19 August 2013 | IPLab2FattyChange7.jpg (file) |  |
65 KB | Peter Anderson | A high-power photomicrograph of the liver parenchyma shows that each individual liver cell is filled with a large, clear droplet which represents the space remaining after lipid was dissolved by the dehydration procedure used to embed the tissue. '''No... | 1 |
| 16:58, 19 August 2013 | IPLab2FattyChange8.jpg (file) |  |
78 KB | Peter Anderson | An oil red O stain for fat was performed on a frozen section of this liver tissue. The red droplets represent fat in the tissue which is typical of fatty degeneration in the liver. By using frozen sections the tissues do not have to be dehydrated throu... | 1 |
| 16:59, 19 August 2013 | IPLab2FattyChange9.jpg (file) |  |
58 KB | Peter Anderson | This photomicrograph of the liver is from another patient with a history of alcohol use. There are some clear vacuoles indicating fat droplets (1) and there are numerous red-staining granular deposits within the cytoplasm of hepatocytes (2)--this is al... | 1 |
| 17:00, 19 August 2013 | IPLab4AtheromatousEmboli1.jpg (file) |  |
31 KB | Seung Park | This is a gross photograph of the aorta from this patient opened lengthwise with the luminal surface visible. Note the rough surface with ulcerations and adherent thrombotic material. There is a mild dilation (aneurysm) at the distal aorta just at the ... | 1 |
| 17:00, 19 August 2013 | IPLab2FattyChange10.jpg (file) |  |
86 KB | Peter Anderson | This is a low-power photomicrograph of liver stained with a trichrome stain. In this section, connective tissue stains green (arrows) and hepatic parenchymal cells are red. Note that many of the parenchymal cells have clear spaces indicating fatty dege... | 1 |
| 17:00, 19 August 2013 | IPLab4AtheromatousEmboli2.jpg (file) |  |
53 KB | Seung Park | This is a closer view of the luminal surface of the aorta from the previous image. The rough, ulcerated surface and the thrombotic material can be easily seen in this image. | 1 |
| 17:00, 19 August 2013 | IPLab2FattyChange11.jpg (file) |  |
58 KB | Peter Anderson | This gross photograph of liver demonstrates severe nodular cirrhosis. Note the extensive scarring of the capsule and the nodular projections of tissue through the uncut capsule in this tissue. The green color is due to the accumulation of bile pigment. | 1 |
| 17:00, 19 August 2013 | IPLab4AtheromatousEmboli3.jpg (file) |  |
34 KB | Seung Park | This is a low-power photomicrograph of kidney tissue. Several blood vessels can be identified at the corticomedullary junction (arrows). | 1 |
| 17:01, 19 August 2013 | IPLab4AtheromatousEmboli4.jpg (file) |  |
78 KB | Seung Park | This higher-power photomicrograph of one of the arcuate arteries reveals a cholesterol embolus. Note the needle-shaped space (arrow) within the lumen of this artery (arrow) which represents the space occupied by the cholesterol crystal that was dissolv... | 1 |
| 17:01, 19 August 2013 | IPLab4AtheromatousEmboli5.jpg (file) |  |
54 KB | Seung Park | This is another view of this vessel with an atherosclerotic embolus. Note the cholesterol clefts (1) and thrombotic material (2) that occlude this artery. | 1 |
| 17:01, 19 August 2013 | IPLab4AtheromatousEmboli6.jpg (file) |  |
62 KB | Seung Park | A mesenteric artery also had an atherosclerotic embolus. Again note the cholesterol clefts and thrombotic material that occlude this artery. | 1 |
| 17:02, 19 August 2013 | IPLab2FattyChange12.jpg (file) |  |
49 KB | Peter Anderson | This is a cut surface of the same tissue seen in the previous slide. Note the marked nodular pattern. The paler-staining areas between the round nodules represent fibrous connective tissue. | 1 |
| 17:18, 19 August 2013 | IPLab5Neurofibromatosis1.jpg (file) |  |
137 KB | Peter Anderson | This photograph, taken at autopsy, demonstrates the distribution of neurofibromas on the skin of this patient. | 1 |
| 17:19, 19 August 2013 | IPLab5Neurofibromatosis2.jpg (file) |  |
40 KB | Peter Anderson | This is another view taken at autopsy demonstrating the neurofibromas. Some lesions can be seen as subcutaneous swellings (arrow) and others form pedunculated masses. Most are hyperpigmented. | 1 |
| 17:19, 19 August 2013 | IPLab5Neurofibromatosis3.jpg (file) |  |
32 KB | Peter Anderson | This is a closer view of neurofibromas on the skin. | 1 |
| 17:19, 19 August 2013 | IPLab5Neurofibromatosis4.jpg (file) |  |
48 KB | Peter Anderson | This is a low-power photomicrograph of a subcutaneous neurofibroma (1). Note the increased pigmentation in the skin (2). | 1 |
| 17:20, 19 August 2013 | IPLab5Neurofibromatosis5.jpg (file) |  |
53 KB | Peter Anderson | This is a higher-power photomicrograph of the neurofibroma (1) with the overlying skin (2). | 1 |
| 17:21, 19 August 2013 | IPLab5Neurofibromatosis6.jpg (file) |  |
89 KB | Peter Anderson | This is a higher-power photomicrograph of the neurofibroma demonstrating the loose pattern of elongated cells making up the tumor mass. | 1 |
| 17:21, 19 August 2013 | IPLab5Neurofibromatosis7.jpg (file) |  |
74 KB | Peter Anderson | This higher-power photomicrograph of the neurofibroma shows more clearly the elongated cells (primarily Schwann cells) that make up this tumor. | 1 |
| 17:22, 19 August 2013 | IPLab5Neurofibromatosis8.jpg (file) | |
59 KB | Peter Anderson | This is a high-power photomicrograph of the cells in the neurofibroma. | 1 |
| 17:39, 19 August 2013 | IPLab5PolycysticKidney1.jpg (file) |  |
48 KB | Peter Anderson | This is a gross photograph of the kidneys from this case. Note that both kidneys contain multiple large cysts (arrows). | 1 |
| 17:40, 19 August 2013 | IPLab5PolycysticKidney2.jpg (file) |  |
26 KB | Peter Anderson | This is a gross photograph of the kidneys from this case. Note that both kidneys contain multiple large cysts (arrows). | 1 |
| 17:49, 19 August 2013 | IPLab5PolycysticKidney3.jpg (file) |  |
33 KB | Peter Anderson | This is a gross photograph of a cut section from one of these polycystic kidneys. Note that the renal parenchyma is almost completely replaced by cystic structures. | 1 |
| 17:51, 19 August 2013 | IPLab5PolycysticKidney4.jpg (file) |  |
69 KB | Peter Anderson | This is a low-power photomicrograph of an H&E-stained section from this polycystic kidney. Note the large cystic structures (1), the few residual glomeruli (2), and the fibrous connective tissue throughout this section. | 1 |
| 17:51, 19 August 2013 | IPLab5PolycysticKidney5.jpg (file) |  |
53 KB | Peter Anderson | This is another low-power photomicrograph of an H&E-stained section from this polycystic kidney. Again note the large cystic structures (arrows)and the fibrous connective tissue throughout this section. | 1 |
| 17:52, 19 August 2013 | IPLab5PolycysticKidney6.jpg (file) |  |
66 KB | Peter Anderson | This is a higher-power photomicrograph of polycystic kidney showing the edge of a large cyst (1). In this section there are numerous tubules and dilated collecting ducts (2) that are filled with the same red proteinaceous material as the larger cysts. | 1 |
| 17:52, 19 August 2013 | IPLab5PolycysticKidney7.jpg (file) |  |
66 KB | Peter Anderson | This high-power photomicrograph shows abnormal glomeruli (arrows) and some tubules. | 1 |
| 17:53, 19 August 2013 | IPLab5PolycysticKidney8.jpg (file) |  |
42 KB | Peter Anderson | This is a gross photograph of the liver from this patient. Multiple cysts can be seen on the surface of this liver (arrows). | 1 |